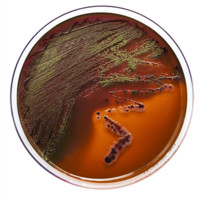
Arv Sin

Company Details
- Employees
- 20
- Founded
- 1992
- Address
- Delhi, Delhi 110034, In
- Phone
- 9999168770
- Industry
- Biotechnology
- Website
- tmmedia.in
- Keywords
- Microbiology, Biotechnology, Pharmaceutical Microbiology, Medical Microbiology, Food Microbiology, Water Microbiology, Dairy Microbiology, Veterinary Microbiology, Brewery & DistMicrobiology, Brewery & Distillery Microbiology, Clinical Microbiology, Environmental Microbiology, Agricultural Microbiology.
- HQ
- Delhi, Delhi